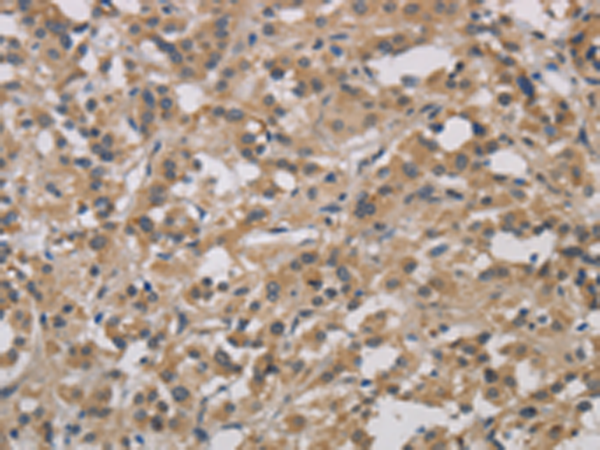
一抗

|
Background: |
The protein encoded by this gene is a small cellular or pericellular matrix proteoglycan that is closely related in structure to biglycan protein. The encoded protein and biglycan are thought to be the result of a gene duplication. This protein is a component of connective tissue, binds to type I collagen fibrils, and plays a role in matrix assembly. It contains one attached glycosaminoglycan chain. This protein is capable of suppressing the growth of various tumor cell lines. There are multiple alternatively spliced transcript variants known for this gene. This gene is a candidate gene for Marfan syndrome. |
|
Applications: |
ELISA, IHC |
|
Name of antibody: |
DCN |
|
Immunogen: |
Fusion protein of human DCN |
|
Full name: |
decorin |
|
Synonyms: |
CSCD; PG40; PGII; PGS2; DSPG2; SLRR1B |
|
SwissProt: |
P07585 |
|
ELISA Recommended dilution: |
2000-5000 |
|
IHC positive control: |
Human thyroid cancer and Human gastric cancer |
|
IHC Recommend dilution: |
50-200 |

 購(gòu)物車(chē)
購(gòu)物車(chē) 幫助
幫助
 021-54845833/15800441009
021-54845833/15800441009